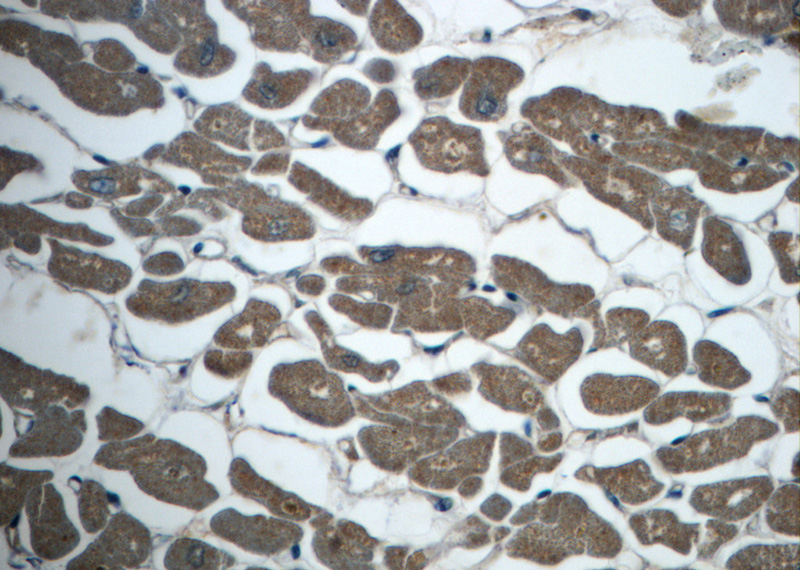
Immunohistochemistry of paraffin-embedded human heart slide using Catalog No:112633(MEF2C Antibody) at dilution of 1:50

-
Product Name
MEF2C antibody
- Documents
-
Description
MEF2C Rabbit Polyclonal antibody. Positive WB detected in HeLa cells, mouse small intestine tissue, mouse testis tissue, rat lymph tissue, SH-SY5Y cells. Positive IHC detected in human heart tissue. Observed molecular weight by Western-blot: 65-68kd
-
Tested applications
ELISA, WB, IHC
-
Species reactivity
Human,Mouse,Rat; other species not tested.
-
Alternative names
MEF2C antibody; myOCyte enhancer factor 2C antibody
-
Isotype
Rabbit IgG
-
Preparation
This antibody was obtained by immunization of MEF2C recombinant protein (Accession Number: BC026341). Purification method: Antigen affinity purified.
-
Clonality
Polyclonal
-
Formulation
PBS with 0.02% sodium azide and 50% glycerol pH 7.3.
-
Storage instructions
Store at -20℃. DO NOT ALIQUOT
-
Applications
Recommended Dilution:
WB: 1:500-1:5000
IHC: 1:20-1:200
-
Validations

HeLa cells were subjected to SDS PAGE followed by western blot with Catalog No:112633(MEF2C antibody) at dilution of 1:500

Immunohistochemistry of paraffin-embedded human heart slide using Catalog No:112633(MEF2C Antibody) at dilution of 1:50
Immunohistochemistry of paraffin-embedded human heart slide using Catalog No:112633(MEF2C Antibody) at dilution of 1:50
-
Background
MEF2C belongs to the MEF2 family. It is a transcription activator which binds specifically to the MEF2 element present in the regulatory regions of many muscle-specific genes. MEF2C controls cardiac morphogenesis and myogenesis, and is also involved in vascular development. It plays an essential role in hippocampal-dependent learning and memory by suppressing the number of excitatory synapses and thus regulating basal and evoked synaptic transmission. It is crucial for normal neuronal development, distribution, and electrical activity in the neocortex and is necessary for proper development of megakaryocytes and platelets and for bone marrow B lymphopoiesis. This protein is required for B-cell survival and proliferation in response to BCR stimulation, efficient IgG1 antibody responses to T-cell-dependent antigens and for normal induction of germinal center B cells. It may also be involved in neurogenesis and in the development of cortical architecture. This antibody is a rabbit polyclonal antibody raised against an internal 161Aa region of human MEF2C.
Related Products / Services
Please note: All products are "FOR RESEARCH USE ONLY AND ARE NOT INTENDED FOR DIAGNOSTIC OR THERAPEUTIC USE"
